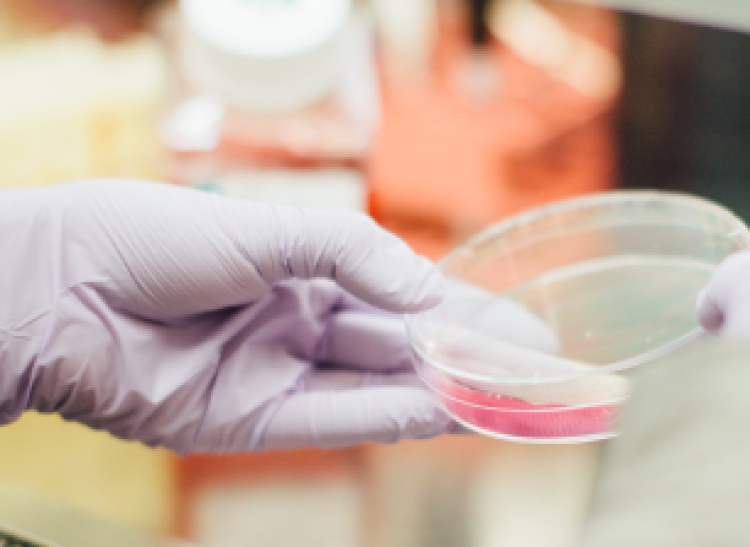
image

About us
- Pharmacoidea Ltd. is a Hungarian biotech company specialized in drug discovery, pharma- and nutraceutical development.
- Our team is comprised of skilled micro-biologists and medical doctors with 10+ years of experience led by Tamas Letoha, MD, PhD.


Safe and innovative therapies
Pharmacoidea's mission is to translate the latest scientific results into practice against diseases with unmet medical needs to promote and preserve health on the broadest scale possible.
Innovative Medicines
- Targeted drug deliver
- Gene therapy
- Neurodegenerative diseases
- Viral infections
Innovative Nutraceuticals
Scientifically and clinically proven dietary supplements with herbal extracts for efficient health protection
NEWS
Latest News
Novel drug delivery technologies of the future
By balazsbajorics
Comments Off on Novel drug delivery technologies of the future
Innovative Medicines Initiative's COMPACT Brussels, Frankfurt, Paris, Utrecht, Ware, Szeged
Hung(a)ry for a new idea?
Hungary's best idea, the Pharmacoidea Ltd. (www.pharmacoidea.eu) proudly sponsors this year's Driving Open